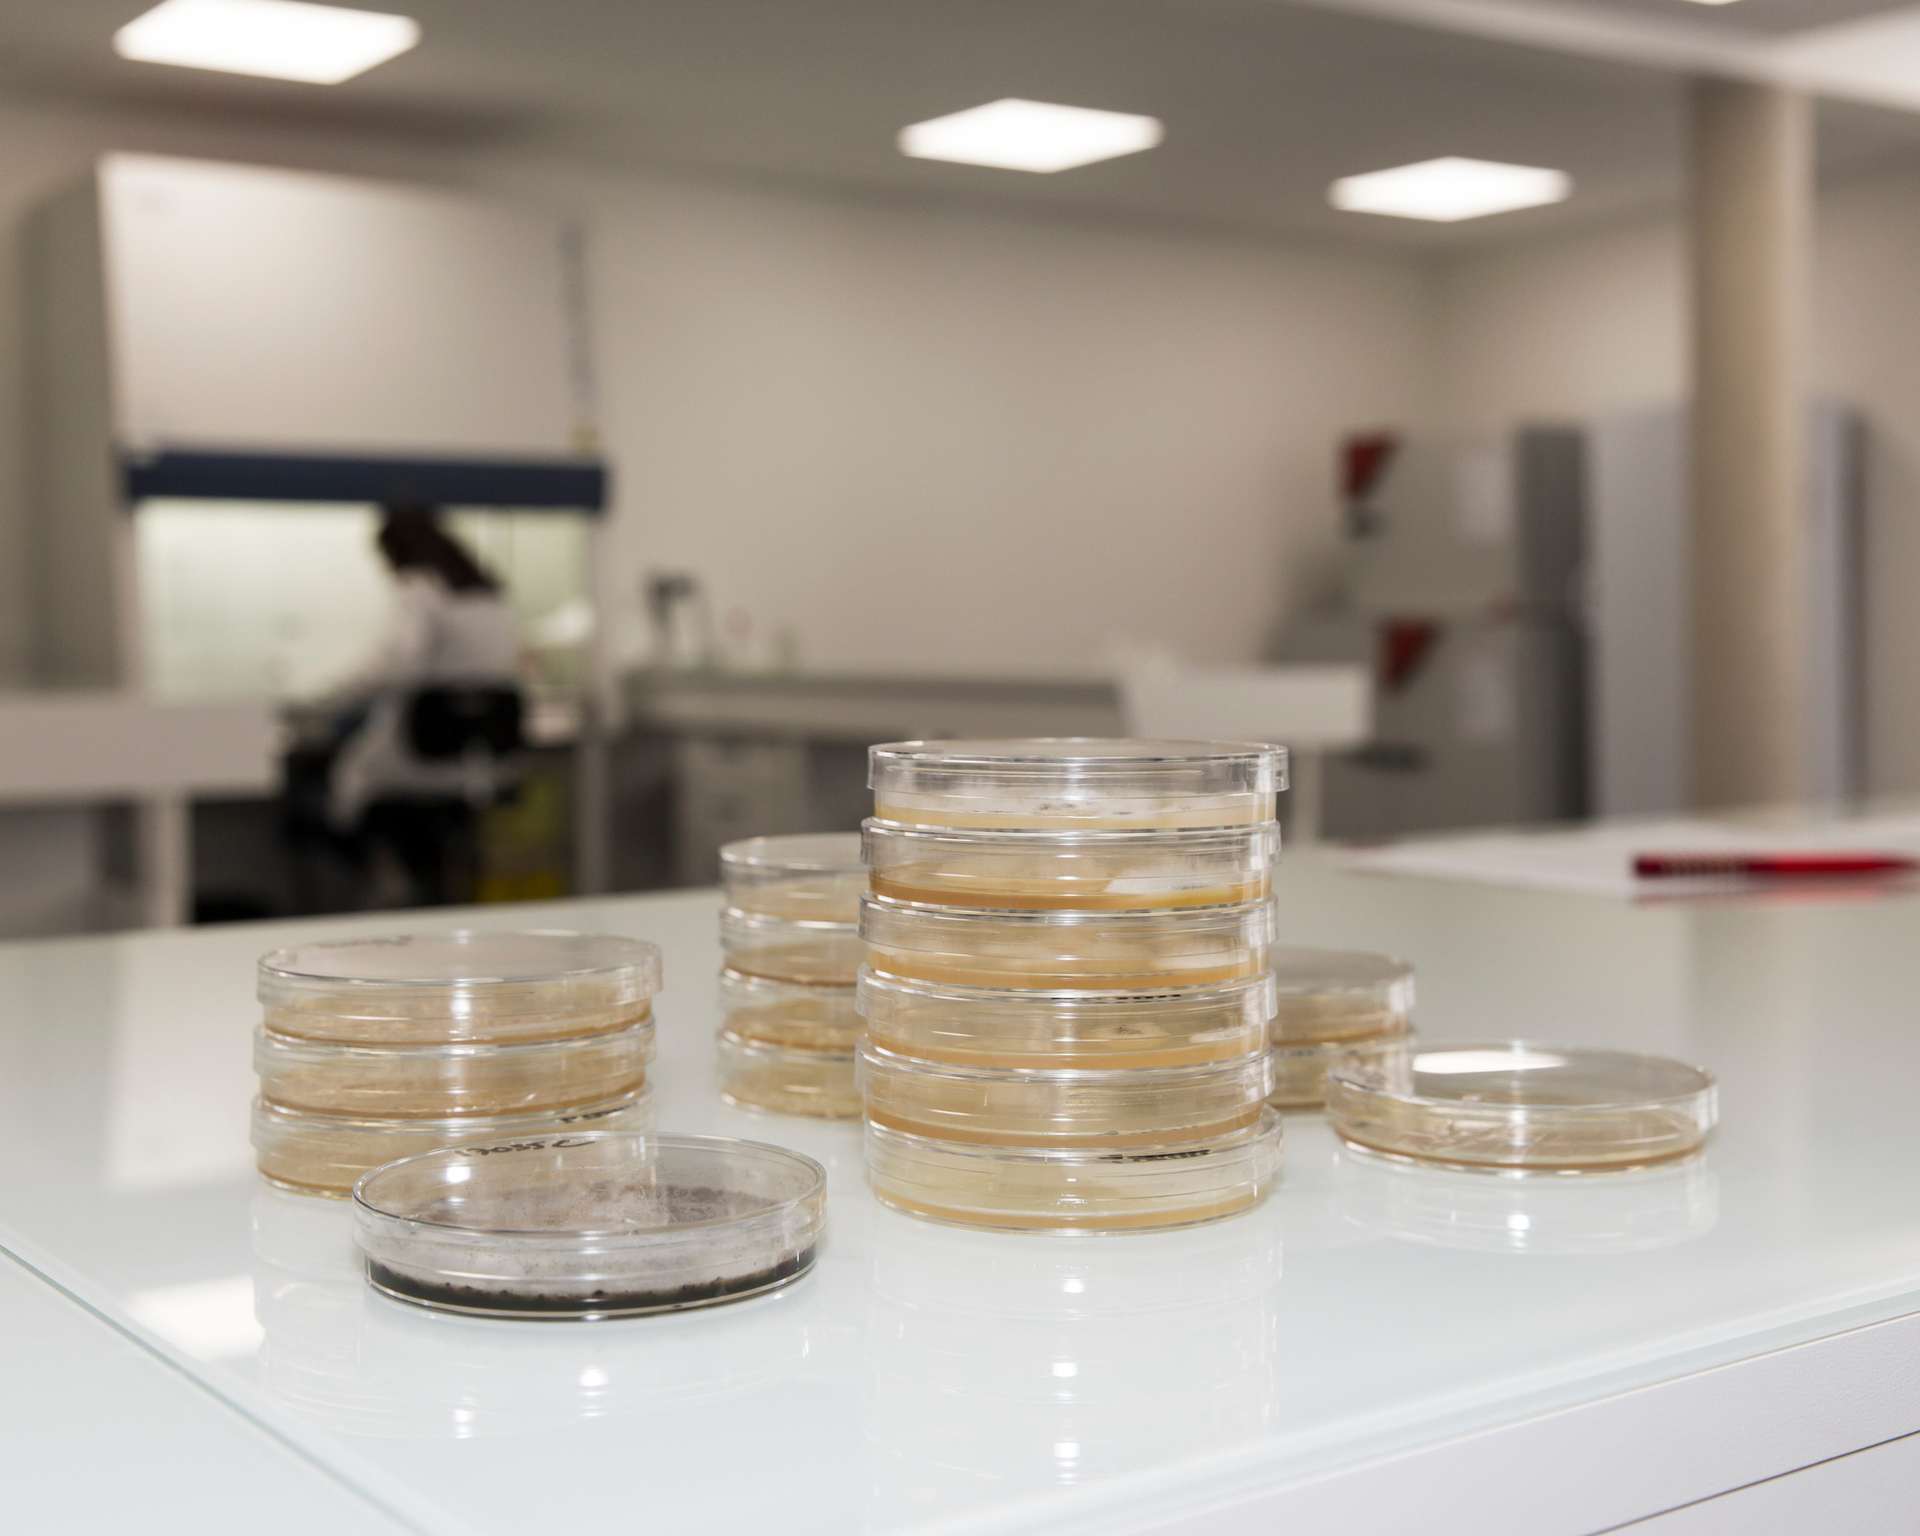
galerie image

Labexan à Cognac 16100 : Adresse, horaires, téléphone
Laboratoire d'Analyses physico-chimiques et microbiologiques spécialisé dans l'analyses des produits cosmétiques, des produits d'entretien, des compléments alimentaire, des produits CBD et analyses fines sur les bois et spiritueux
Voir le site
Contacter
- Tel :
Y aller
Horaires
Les horaires d’ouverture de Labexan, sont fournis à titre informatif, hors périodes de congés. Pour être certain de ces horaires, veuillez contacter directement l’établissement.
- Lundi
09:00-13:00
14:00-18:00 - Mardi
09:00-13:00
14:00-18:00 - Mercredi
09:00-13:00
14:00-18:00 - Jeudi
09:00-13:00
14:00-18:00 - Vendredi
09:00-13:00
14:00-18:00 - Samedi
Fermé
- Dimanche
Fermé
la proposition a été envoyée
Langues parlées
- fr
A proximité